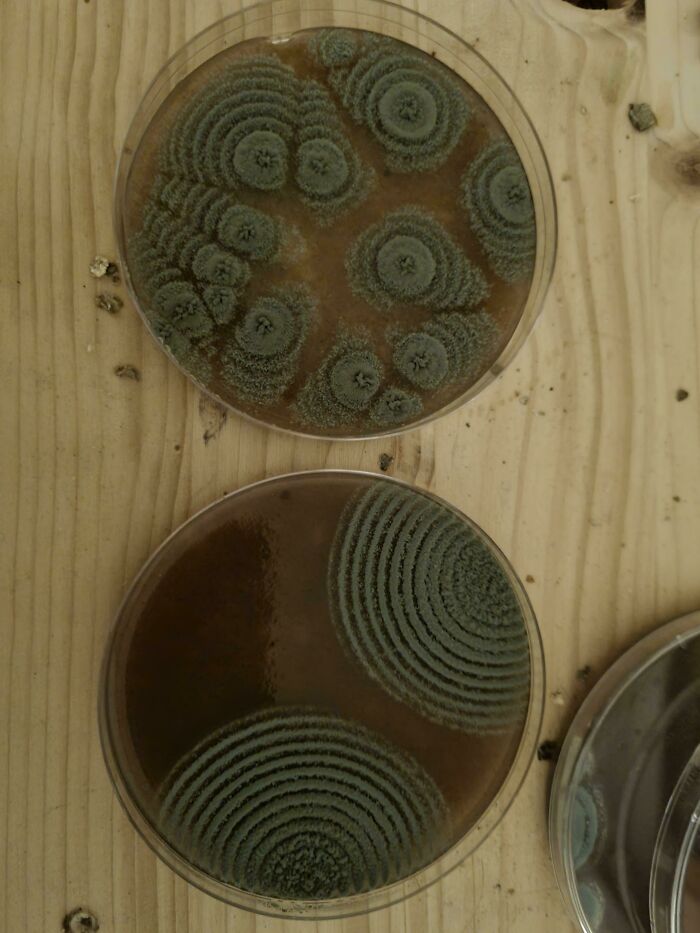
I Had Prepared A Few Agar Plates And Stored Them In A Poorly Sterilized Bag For A While. Now It Has Become Art
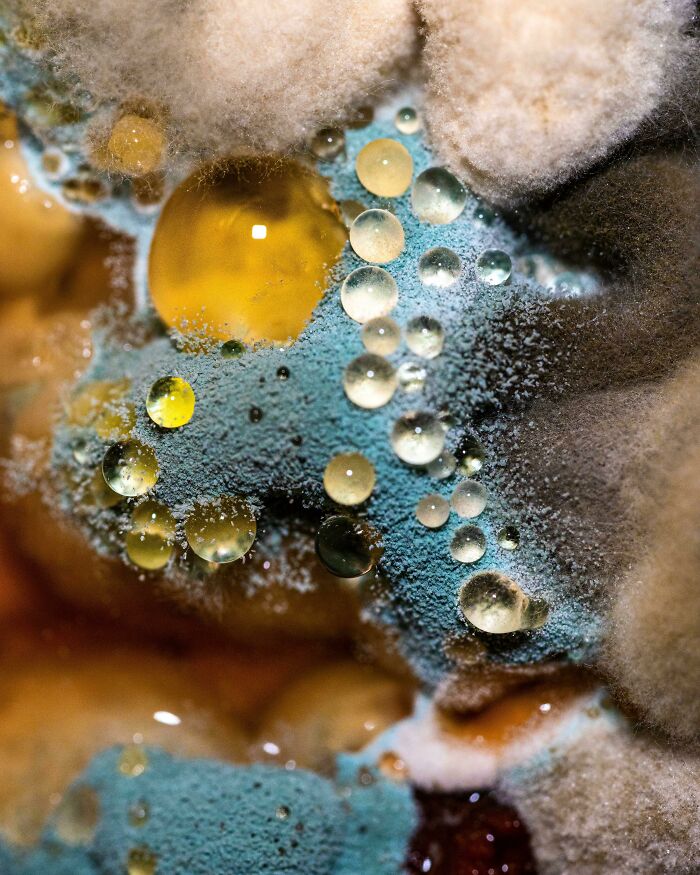
Vegan Chili Forgotten In The Garage Fridge
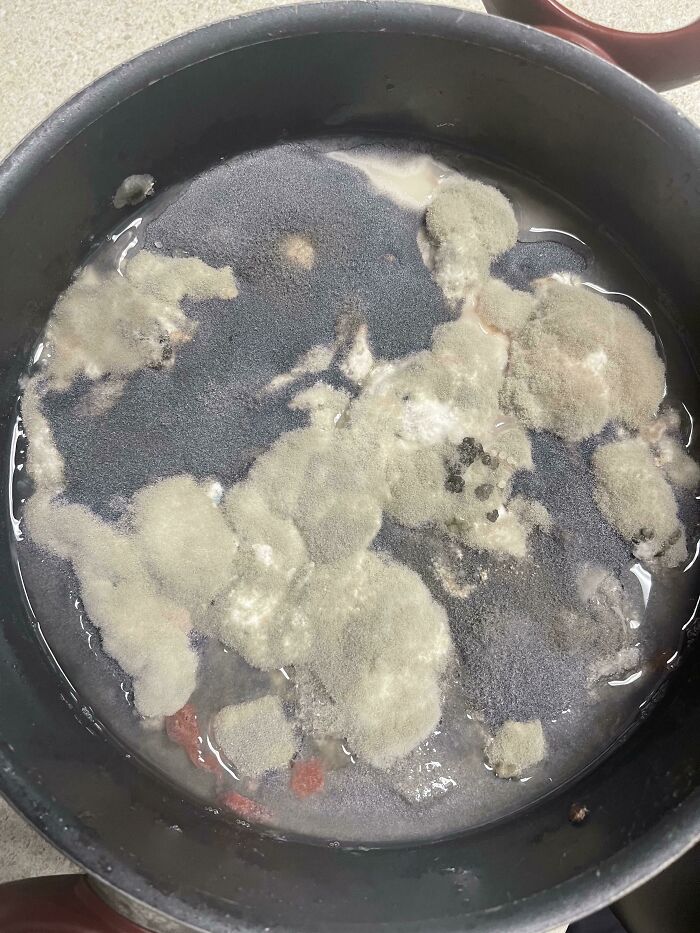
Free Upvote For Guessing What This Used To Be

Our planet is such an amazing place. There are so many wonders surrounding us, and yet still so much that remains unknown, just waiting to be discovered. Interestingly, some of the most fascinating things are right at our fingertips.
An online group called "Moldly Interesting" is a great example of that! With over 250k active members, the community proves that something as ordinary as mold can still surprise us. This is the place dedicated to the most "moldy" content, where people share some intriguing-looking forms of mold. Scroll down and check out the list of images we've prepared for you, and we guarantee you will be asking yourself, "What have I just seen?"
Also, if you’re interested in learning some cool facts about mold, we have reached out to Dasha Plesen, who is an expert in this field, so make sure to read our interview.
This post may include affiliate links.
Colourful Mold
This Jack O Lantern With Mold Growing From Inside
This Mold Looks Like A Baby Seal
Bored Panda recently connected with Dasha Plesen, an artist known for creating mesmerizing art pieces with mold as their centerpiece. On her Instagram profile, the artist shares process videos as well as photos showcasing the final results of her work. Dasha's molds take on different forms, textures, and colors, serving as inspiration for her ongoing creations.
Initially, the artist preserves her samples by encapsulating them in resin. Later, the visual outcomes of these creations take on a new life, transforming into colorful prints on fabric, framed pieces of art, and stylish home decor.
I Had Prepared A Few Agar Plates And Stored Them In A Poorly Sterilized Bag For A While. Now It Has Become Art
Not Mine, But Happy Holidays Everyone. 🎄
A Tin Of Cat Food Left Out Created Some Bizarre And Creepy Mold
We were extremely curious to find out how Plesen became interested in using mold as a medium in her artwork. She shared with us: “Firstly I am a big fan of science, lab aesthetics, surgical operations, genetic experiments, and cosmos, but as for this idea, it was 8 years ago when I was meditating on the first course at uni when we needed to think about our final major project exhibition concept and just accidentally got a vision of petri dishes and collecting samples! (Through the last chakra we can be connected to the big field of everything, like quantum ether, and you can have all answers, ideas, and everything from there).Also, I think it's because I was planning to run a medical course after school and my neurons gave me such thoughts, because of past experience and desires.”
I Was Out Of Commission With Pneumonia For A Week And A Half. Got Up To Clean House When I Discovered This. It Seemed Like I Could Pet It Like A Dog. Insane
Swab Taken From The Bottom Of My Lab Partner's Shoe Grew This Masterpiece
Mold
Asked how the artist manages the growth and maintenance of mold in her work to achieve the desired effects, Dasha said: “It's mostly time, my super attention, daily checkups, and complete trust in nature plus my skill, interest, passion, love, and belief.”
We were wondering what types of mold Plesen works with and their unique characteristics. We found out: “I do not categorize them because I'm interested in their visual appearance, colors, the way they communicate, develop, disappear, so for me, it's a parallel to relations with people. I do not care about species aspects, like skin tone, race, weight, height, hair color, eye color - I'm interested in the full, I accept and I love, no matter what. Unique characteristics are the way they gently touch each other when they grow, how they transport the color inside the body, and how they develop in time. Also, the imagery is very new every time and it stimulates my dopamine system extremely hard. Also, an interesting moment is pareidolia, when I see faces, letters, manuscripts, and codes inside the petri dish. One day I want to make my own alphabet with decrypted symbols!
But, of course, when it comes to special projects where we need to cultivate only one type - I should know the name and morphology 100 percent.”
My Friend Just Found This In His Fridge. He Thinks It Was Mashed Potatoes At One Point
Pineapple With A Staring Problem
Mold Is Evolving
Looks like the beginning of a scifi movie, where someones starts to shrink and falls into the coffee..
We also wanted to know how Dasha views the connection between art and science in her mold-based creations. She explained: “I see this as a super potential for both science and art because it's a field that is free from any borders. Science has tech equipment and facilities, art has freedom and culture. Make them dance together - new age matter for all creative and intellectual fields made! For me, it's like a golden section of creative interconnection, because it could be expanded to dozens of absolutely different plots and expand people's understanding, vision, and life!”
This Decorative Gourd Started Molding In An Interesting Way 👽
Moldy Watermelon Juice Breeds Little Jiggly Puffs
The Mold In My Marmalade This Morning
We also reached out to the Australian biologist and lab tech, Anita Marie Poupa, to learn more about molds. First, we asked the expert to explain the life cycle and growth patterns of molds. Here's what we discovered: "Molds belong to the kingdom of fungi and reproduce by releasing tiny spores into their surrounding environment, which can be dispersed via the wind, water, or by hitching a ride on animals.
There are many different species of mold, and they thrive in moist environments. When spores land on a suitably damp surface, they germinate, and the organism will grow a network of thin, thread-like structures called hyphae. If spores land in a dry area, they will remain inactive until they can absorb moisture. The hyphae grow immediately after germination, forming a mass called the mycelium, which extracts nutrients from the substrate. Finally, reproductive structures are formed, from which the spores are released."
Black Pin Mold That Spawned From A Bowl Of Cat Food That Has Been Soaked In Water For A Few Weeks
Is this how the cat distribution system works? Leave out food long enough and you just grow your own cat?
My English Muffin's Mold Looks Like A Sunflower
Mold On Cream Cheese
We also inquired about the potential health risks associated with mold exposure. Anita explained: "We constantly breathe in airborne spores, and our immune systems are equipped to deal with this. However, exposure to high quantities of harmful mold species or individuals with allergies, sensitivities, compromised immunity, or respiratory issues such as asthma may face health problems. Black mold is the most commonly known type that affects households. Areas in the home prone to mold growth include places where condensation builds up, like windows, kitchens, and bathrooms, areas that have suffered from flooding or water damage, or places with poor airflow. Controlling moisture is crucial to keeping mold levels under control. Ensure all areas and items are regularly aired out and dried thoroughly to prevent ongoing humidity."
"Wipe away mold as soon as it appears using mold-killing products, and if you experience unexplained or worsening health issues, consult your doctor. Mold exposure can result in various symptoms, including allergy-like symptoms such as eye/skin/respiratory irritation, coughing, wheezing, and a runny nose, as well as other generalized symptoms like fatigue, brain fog, stomach issues, and muscle pain. The source of the mold in your building may not be visually obvious or easily accessible, so consider consulting mold experts in your area and having inspections conducted."
Not Mine, Cool As Hell
Agar plate, someone has had a lot of fun growing that flower garden.
Crazy Mold We Got Growing From Under Our Deck
Friendly (?) Neighborhood Slime Mold
We also asked the Australian biologist about how molds contribute to the natural environment, including their roles in decomposition and nutrient cycling. Here's what she told us: "Molds (and other fungi) play a crucial role in nature. They are capable of decomposing organic matter, such as fallen leaves and trees, which can be challenging due to the presence of hard-to-break-down cellulose in plants. They recycle nutrients and essential building blocks back into the soil and the environment, making them available for plants to use again. Imagine if fallen plant matter never broke down, or if the soil ran out of nutrients for plants."
I Clean Up Mold For A Living, This Is Some Of The Worst I’ve Ever Seen
I Work In A Plant Tissue Culture Lab. Contamination Sucks, But Sometimes It’s Beautiful!
My Friend Left Some Rice In This Pot And Put It In The Back Of Her Cupboard. This Is What She Found Yesterday
Lastly, Anita added: "Modern medicine greatly benefits from some types of mold. For example, without molds from the Penicillium genus, we wouldn't have the highly effective antibiotic penicillin, which has saved millions of lives. Just like with animals and plants, the key with molds and other fungi is to be aware of which ones are potentially harmful without creating unnecessary fear or phobia towards all of them. Each has its place and role to play, but preferably not inside your home!"
Sorry I Just Had To 🥰
Heard You Guys Would Enjoy This Here, Car Parked Next To Me, Hasn’t Been Moved In Months, Took A Look Inside…
Film Of Mold On Water
Fuzzy Strawberries And One Seemingly Immune Strawberry
That lone strawberry probably started the mold and is acting innocent lol
"Who, meeeee? I'm just a lil 'ol strawberry here in the corner, sweet as can be!"
Load More Replies...Poor strawberry...had to watch his family die and be overtaken. The trauma she has seen.
Til Highlithers Can Grow Mold
Forgot About A Can Of Wolf Brand Chili In Back Of Fridge And The Mold Growing Looks Like Wolf Hair
Where did you think wolves came from? Go put it in the yard so it can find its pack!
Canned Peaches
The Previous Tenant Never Mentioned To Their Landlord That The Toilet Upstairs Was Leaking For 3 Years
This Mold Growing On Some Spam
The Nifty Kiwi Seed Like Mold Growing From Some Kiwi 🥝
Found On A Very Old Instant Coffee . Trying To Identify What It Is
Art Of Molds😍🧫💎💕
A Family Of Happy Mice. (I Forgot A Box Of Strawberries In The Fridge Before Leaving Home A Month Ago)
This Spaghetti Grew Green Hair
Congratulations. I've seen angel-har pasta. You have troll-hair pasta.
Found In A Forgotten Closet
This Used To Be Red Wine
In The Back Of My Moms Fridge
Our Dried Maitakes Weren’t Dried Enough It Seems
Mushrooms contain a lot of water, and mold requires surprisingly little.
Meet Melvin. We Found Him Growing In The Compost Bin
Hair Or Mold?
A Forgotten Lemon
Left This Loaf Of Sourdough Bread Unattended For Just 6 Days. Wasn't Expecting This When I Opened The Bread Box
Never put baked goods in airtight sealed containers! Better slightly dry bread than mold infestation
Should I Be Alarmed?
This Moldy Spider I Found While Cleaning My Shed
That's a zombie spider I don't know too much about them other than they get infected and start coming back to life but surrounded by mold
Strawberries In A Pyrex
Jar Of Sugar Left In Storage For 20 Years
This Mold On My Bread Looks Like It's Trying To Disguise Itself As A Boiled Egg
The Only Island I Can Afford
I've Been Sick And Didn't Have The Energy To Clean My Room Until Now, And Me And My Dad Thought It Looked Interesting!
Too Soon? 🎃
Forgot Spaghetti With Mushrooms In The Microwave For A Week. Now It's A Floofly Ball Of Mold
Cat Sick That Was Left To Mature For A Few Days 😰
Well, it looks like the mold growing on the opened cat food. Coincidence? 🧐
A Fuzzy Steering Wheel Cover?
Work Has Been Neglecting The Salami Kitchen…
Oh no! (But isn’t that expected on salami, just in lesser quantities?)
Cleaned Out The Fridge Today And Found This Hidden On The Back Of The Top Shelf - This Used To Be Vegan Cream Cheese
Sister Used My iPad And I Later Found It In This Condition, This Is Mold Right? I Wiped It Down With A Wet Wipe, Is That Good Enough?
Mesmerizing Old Sourdough Starter I Found In The Fridge
Growing In The Toilet
Even If Spoiled, It Still Proved To Be Useful :)
Care For A Slice?
My Beans Turned To Brains
Heading To France Tomorrow. Found This Well Matured Camembert From A Year Ago In My Luggage
Chicken Sausage I Forgot About For A While
Extremely Moldy Turkey
Forgotten Rice Cooker
Vegan Chili Forgotten In The Garage Fridge
Does This Look Like Mold?
I Present You: The Nespresso Mold
Free Upvote For Guessing What This Used To Be
OMG. I never knew that mold came in so many shapes and colours. I'm beginning to suspect that very few of these are native to my country. Beautiful article, BP.
I scrolled all the way down here first to ask why am I about to do this to myself. Ok, here goes.
This was soo disgusting, but i couldn't look away. People need to clean our their fridges regularly.
we recently learned, after five years, that the bathroom fans in our house don't vent out of the roof, but instead just blow directly into the crawlspace attic. I feel like this is good prep for what we're going to find up there.
The ones that have repeating circles... how do we know they aren't mini tiny farms and the mold aliens are just trying to grow corn for their supper?
OMG. I never knew that mold came in so many shapes and colours. I'm beginning to suspect that very few of these are native to my country. Beautiful article, BP.
I scrolled all the way down here first to ask why am I about to do this to myself. Ok, here goes.
This was soo disgusting, but i couldn't look away. People need to clean our their fridges regularly.
we recently learned, after five years, that the bathroom fans in our house don't vent out of the roof, but instead just blow directly into the crawlspace attic. I feel like this is good prep for what we're going to find up there.
The ones that have repeating circles... how do we know they aren't mini tiny farms and the mold aliens are just trying to grow corn for their supper?

 Dark Mode
Dark Mode 

 No fees, cancel anytime
No fees, cancel anytime